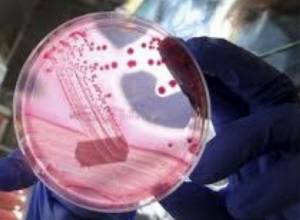
Beansprouts likely cause of deadly E. Coli outbreak

Seven-year-old injured passenger undergoes another operation
Seven-year-old Gor Hayrapetyan, one of the passengers injured in a major road accident in Yerevan's Artsakh Street, underwent another surgery last week.
More citizens diagnosed with enteric infection in Yerevan
As of June 6, there are 55 patients diagnosed with an enteric bacterial infection in Yerevan's Nork Infection Hospital, including 14 adults and 42 children.
Beansprouts likely cause of deadly E. Coli outbreak
Beansprouts grown in northern Germany are said to be the source of an E. coli outbreak throughout Europe.
Hail expected in Armenia
Short rain and thunderstorm are expected in Armenia at the weekend
P.S. to host political technologist
ou can send your questions to [email protected] or call at 58 54 27.
Tree falls on passers-by in Yerevan
A poplar fell on a house damaging a nearby car as a result of yesterday's severe storm in the city of Gyumri, Armenia.
Four injured in road accident
The driver and passengers of the Mercedes were taken to Hospital N1 in Vanadzor.
“Thank you for banning smoking in public places”
Anti-smoking campaign will be held in Yerevan on June 4, 2011.
Your questions for Ara Papyan
You can send your questions by calling us at 58-54-27 or sending an e-mail to [email protected].
TOEFL not required
The deadline for Regional Master's Program in Human Rights and Democratization in Armenia Belarus, Moldova and Ukraine application submission has been extended up to 10 June 2011.
Try your luck today
The first person to find his or her item during a lottery will get married soon.
Life in prison cases are a taboo?
"From the humanistic angle, those people should have the opportunity to correct themselves and get out of prison after a while," said Avetik Ishkhanyan.
“Barekendan” around the world
Hovhannes Tumanyan's "Tern u Tsaran" (Master and the Servant) will soon be translated into several languages.
Candidate appealed to Administrative Court
"I will restore justice," said the village head candidate.
They sleep in turns
Penitentiaries registered 7 deaths in 2009 and 35 in 2010.
Do you want to have a weapon?
Ask Deputy Colonel of the RA Police Tigran Amiryan any question related to weapons.
Outflow of Azat, Arpa and Yeghegis
The heads of the corresponding regional councils have been informed of the incidents.
Why was statue of Andranik demolished?
Demolishing the statue of a national hero is, to say the least humiliating, if not treason," as stated in the statement.
Schoolboy attempts bank roberry in Ijevan
A 17-year-old schoolboy tried to rob a bank in Ijevan city, Armenia, on June 1.
P.S. to host Stepan Safaryan
You can send your questions to [email protected] or call at 58 54 27.
When the magic stick is in the hands of children
"I would like to become the master of the universe," said little Garik.
Yerevan Metro operating as per usual
Yerevan Metro is operating as per usual; all technical issues have been recovered
One injured as cars falls into gorge
A 39-year-old man was injured as the Volkswagen he was driving skidded off the road and fell into a gorge on Yerevan-Gyumri roadway
Two people hospitalized after snake bite
David Ghazaryan, a resident of Byurakan village, was taken to hospital after snake bite on May 31.